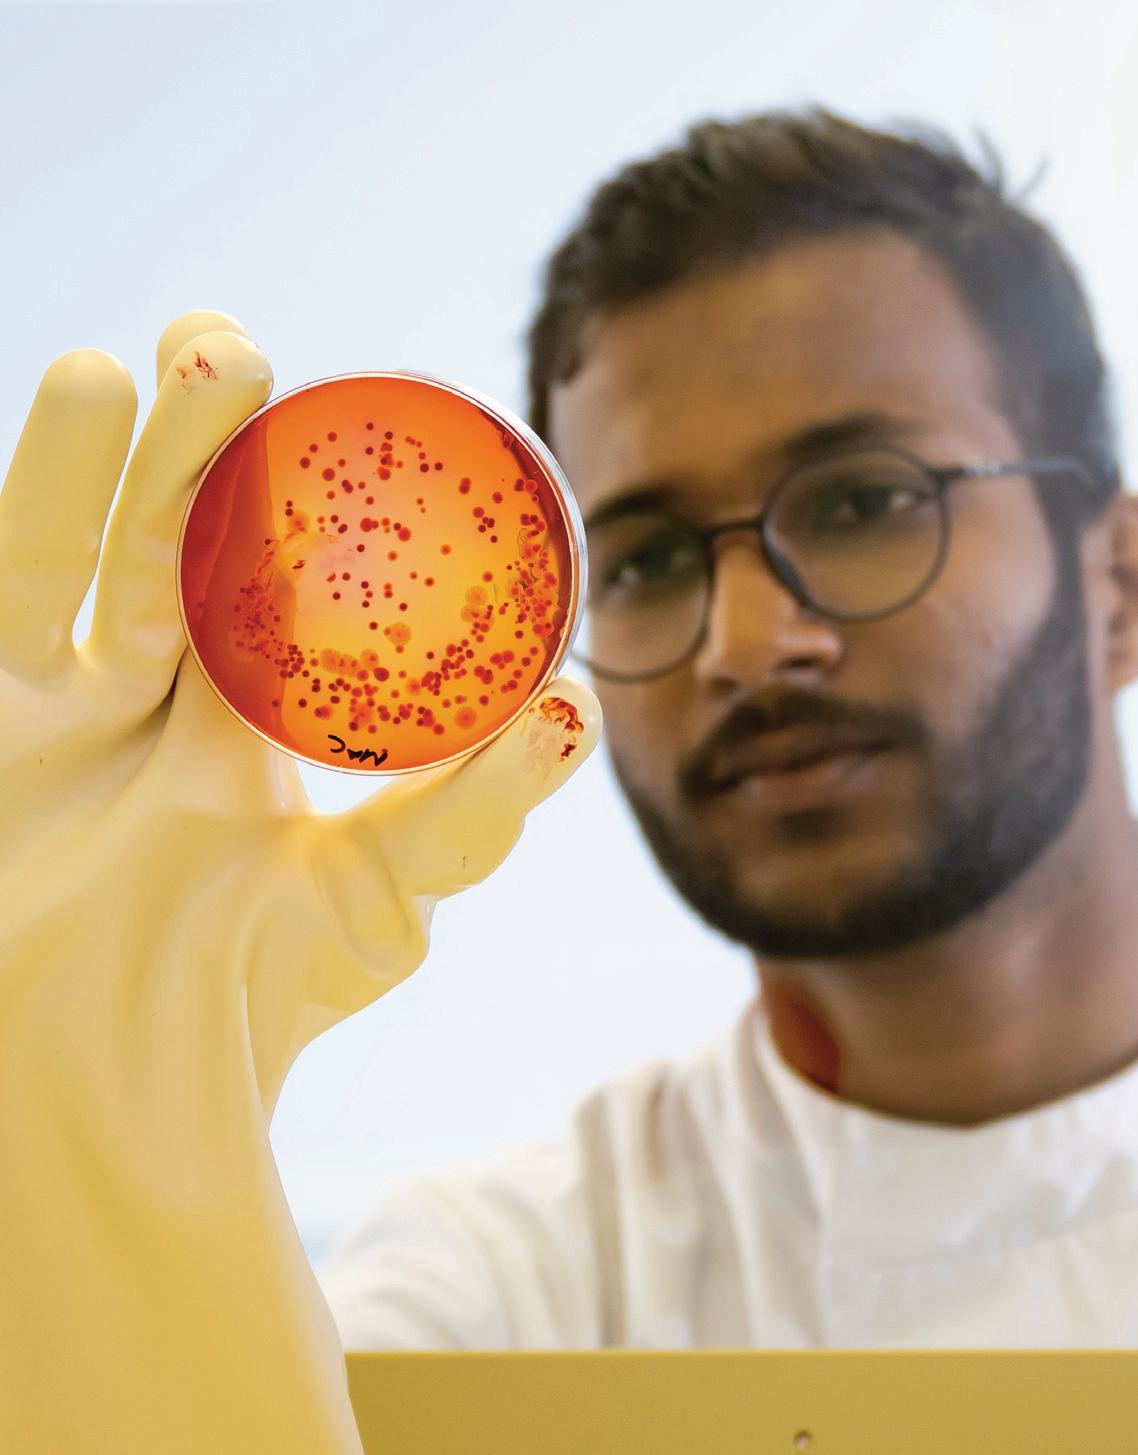

International Guide 2025/26


![]()
International Guide 2025/26



Your time at university is about more than just earning a degree. It’s about finding a place where you can thrive.
Where you make friends that become family. Where you’re both challenged and nurtured, instilling you with confidence to make your way in the world. Where you experience a sense of belonging that stays with you long after you graduate.

Top 10 UK university for international students*
Students say they love our friendly, diverse academic community, our teaching staff, as well as studying in the capital city of Wales.
* Ranked 8th in the Whatuni Student Choice Awards 2024

Affordable UK city
Cardiff is easy on your budget – since 2017, the Welsh capital has been regularly rated as one of the most affordable student cities in the UK, according to the NatWest Student Living Index.
Strong international links
Study with us and you’ll become part of a diverse community with students from over 100 countries, giving you the chance to make lasting friendships with different people from all over the world.
Preparing you for life after university 96.3% of our graduates are in work or further study 15 months after completing their course*.
* Graduate Outcomes Survey, June 2024

Ranked best – and friendliest –city in the UK
Cardiff was named as both the UK’s best and friendliest city in the 2023 Condé Nast Traveller Readers’ Choice Awards.
A city for students
A compact, easy-to-navigate space, Cardiff is full of culture, adventure, good food and sport – as well as a large student population that thrives in the city’s fun and vibrant atmosphere.


To help you get settled in, our student support teams offer advice on everything from choosing the correct visa and finding accommodation to travelling to Cardiff. Our warm and welcoming service has resulted in us being ranked 10th in the Whatuni Student Choice Awards 2024 for student support.
Leading university for student sport
You’ll be supported whatever level you’re at, whether you’re a beginner or competing in a national championship.
Our ambitious environmental and ethical performance has resulted in Cardiff Met being ranked 6th in the UK for sustainability in the People & Planet University League 2023/24.
Our excellent, purpose-built facilities were ranked 5th in the UK by the Whatuni Student Choice Awards 2024.
Scholarships for international students
As an international student, you’re eligible for a number of scholarships and studentships to support your undergraduate or postgraduate study. See page 27 for more details or visit our website for full eligibility criteria and how to apply.



Want to learn more about student life at Cardiff Met?
Hear what it’s like from real students in our podcast, Help! I’m Going to Uni

Scan or click to visit our podcast

There’s a reason so many students remain in Cardiff after graduation: the Welsh capital is a welcoming, lively and affordable place to call home.

A city made for exploring
Flat and compact, Cardiff is incredibly easy to explore. Most of the city centre is pedestrianised, and the coastal charms of Cardiff Bay are only a 15 minute walk away. Buses and cycle paths weave throughout the city, and you can grab a ticket at any of Cardiff’s 20 railway stations to easily reach the rest of Wales and the UK.
A city for nature lovers
Across the capital, you can explore over 330 parks and green spaces – including Bute Park, known as the ‘green heart of the city’ – where many of our students can be found having picnics or lazy strolls on a warm spring day. If you’re feeling adventurous, you can walk or cycle up the 55 mile-long Taff Trail, which runs from Cardiff all the way up to Brecon.

Want to head further afield?
In less than an hour from the city, you can be surrounded by stunning beaches and national parks, ideal for an afternoon spent taking in the spectacular landscape Wales is known for. And London is only two hours away by train.
A city for food lovers
In recent years, the capital has grown to become a major foodie destination. Here, big-name chains and independent restaurants are dotted all over the city –locals love the street food vendors at Cardiff Market (built in the 1700s) and the many bars and cafés found in the Victorian and Edwardian shopping arcades.
A city for sport
Sport is a way of life here in Cardiff, and the atmosphere is buzzing come game day, when enthusiastic fans flock to world-class sporting venues across the city to cheer on their favourite teams – there’s Welsh Rugby Union at Principality Stadium, football at Cardiff City Stadium or cricket at the Sophia Gardens Stadium, Cardiff.

Cardiff was named as both the UK’s best and friendliest city in the 2023 Condé Nast Traveller Readers’ Choice Awards.
With a rich cultural heritage, a variety of museums – many of them free – and a castle right in the centre of the city, Cardiff is a place where it’s almost impossible to get bored.
There’s theatre and opera at the iconic Wales Millenium Centre, films showing across three multiplex movie theatres, live comedy at the Glee Club and plenty of gigs at venues large and small. If it’s musical heavyweights you’re after, the Principality Stadium, the biggest venue in Wales, has recently welcomed the likes of Taylor Swift, Pink, Bruce Springsteen, Foo Fighters and Billy Joel.
In the warm summer months, you can experience a series of open-air concerts at Cardiff Castle, which offers a striking setting for late-night revelry.

Chapter Arts Centre, located in the suburb of Canton, is a much-loved hub for contemporary arts and culture, with a gallery, theatre spaces, cinema, café and a programme of classes, workshop and events.
As a capital city, Cardiff also hosts a number of festivals and cultural events throughout the year that bring together thousands of people of all ages and backgrounds.
Approximate driving times

At Cardiff Met, you’ll have the freedom to shape your student experience into one you’ll never forget.
Through Cardiff Met Sport and Cardiff Met Students’ Union, you’ll get endless opportunities to discover something new – or get even better at what you love. And, in doing so, you’ll discover a close-knit community of people who share your passions, whether you’re into arts and crafts, watching cricket or improving your fitness.
Once you enrol as a student here, you automatically become a member of the Cardiff Met Students’ Union (SU).
With over 30 clubs and societies to choose from (and there’s no limit on how many you can join), you can pursue that hobby, campaign for a cause or try something completely outside of your comfort zone. Can’t find what you’re looking for? If you want to start your own club or society, the SU can help you set it up.
You can also learn new skills and get to know people outside your course through the SU’s programme of events held during term time. Or meet friends for a drink or game of table tennis at Centro, the SU cafe´, bar and lounge on Cyncoed Campus.


Learn more about life as a Cardiff Met student:
www.cardiffmetsu.co.uk
Join the SU community

*Correct at time of print (September 2024)
Wales’ sporting university
Mad about sport? Then you’ve come to the right place. Cardiff Met has a rich heritage of sporting excellence, and here you’ll be fully supported in your athletic ambitions, whatever they may be.
Whether you’re hoping to improve your flexibility or train for the next Olympics, our facilities and team of fully trained staff can help you reach your fitness goals faster.
Our specialist equipment and work out spaces include a multi-purpose sports arena, strength and conditioning suites, and fully inclusive fitness centre. We’re also home to the National Indoor Athletics Centre (NIAC).

Free sports and fitness membership for students
Met Active, our sports and fitness membership scheme, is free to Cardiff Met students in the 2025/26 academic
The scheme includes full use of our gyms, swimming pool and fitness classes, ranging from indoor cycling and weight lifting to Pilates and yoga.
Join a sports club
With more than 30 recreational activities to choose from – including cheerleading, boxing and surfing – you can get fit and make new friends in a fun, supportive environment. And beginners are always welcome.
As part of our Cardiff Met Performance Sport programmes, we attract elite athletes from across the globe looking to combine sports with their academic pursuits. Our programmes are led by members of staff and coaches with years of experience working with student athletes.
We’ve been recognised by the Talented Athlete Scholarship Scheme (TASS) Dual Career Accreditation Scheme, which supports students operating at the highest levels of sport.
We’re here to help you balance your hectic training and competition schedule with the academic demands of university life. If you qualify, you’ll have a degree of flexibility to help meet those demands – so you could, for example, submit coursework late or take an assessment in a different format.
Performance Programmes
Athletics
Women’s Basketball
Wheelchair Basketball
Men’s Cricket (Cardiff University Cricket Centre of Excellence, UCCE)
Men’s Football
Women’s Football
Men’s Hockey
Women’s Hockey
Netball
Men’s Rugby Union
Women’s Rugby Union
Triathlon
Performance and elite sports scholarships
With our generous sports scholarships, you can get financial support to help you achieve your athletic potential without compromising your studies.



At Cardiff Met, you have lots of options when it comes to choosing your home away from home.
Not sure where to start? You can enlist the help of our specialist team dedicated to helping our international students find the best place to fit their preferences and budget.
They’re part of a wider team of accommodation staff who look after all our students – wherever they decide to live – from the moment they apply, right up until they graduate.

Scan or click to visit accommodation
We offer study bedrooms in large blocks of flats – known as ‘halls of residence’ – across our Cyncoed and Plas Gwyn Campuses. It’s not only one of the most affordable options when it comes to student living, but also a great way to get to know people on different courses.
You’ll be allocated a room based on where you’ll study, living alongside around seven students of mixed genders. You’ll have your own room but share a kitchen space and bathroom facilities with your flatmates. Or you can apply for a room with its own bathroom (called an ‘ensuite bedroom’).
The weekly rate covers all utilities, including WiFi, and home insurance. There’s also a ‘catered’ option, which includes breakfast and dinner at our on-campus restaurant seven days a week during term time.
Please note that rooms are subject to availability and are normally allocated on a first-come, first-served basis.
You can also apply for an ensuite study bedroom in privately-owned halls of residence here in the city. You will usually be in flats with other Cardiff Met students. Some private halls are located close to our campuses, while others are only a short bus ride away and are closer to the city centre.
You can find out more about our halls of residence, including costs, on our website at: www.cardiffmet.ac.uk/accommodation
How to apply for a room in our halls of residence or private halls
Once you’ve received an offer from us, you can apply from 1 April via our website.
Private sector accommodation
You can also rent a private house or flat from a landlord or letting agent. We can provide you with a list of landlords who meet all of the legislative requirements to rent their houses. And we can give you advice on rental contracts and what to look for.



We’re here to help you make the most of your time at university. If you need a bit of extra support, our specialist teams offer free, impartial and confidential advice on a range of issues. They’re easy to contact, and also easy to talk to.
exclusively for international students
As an international student, you’ll have a dedicated team on hand to support you throughout your studies –everything from applying for your visa to finding accommodation.
And to help you get settled in, you’ll be invited to take part in our International Student Welcome event, where you’ll meet other students, key members of staff and receive essential information about living in Cardiff and adapting to a new culture.
You can also join the team’s many
Study, work or volunteer abroad
Want to see even more of the world?
As part of, or alongside, your degree you can study, work or volunteer abroad. We offer scholarships too, if you need help funding your travels.
Living like a local in an unfamiliar place (as you’ll soon find out if you study here) has so many advantages – like learning new skills, making lifelong friends, building your confidence and improving your employability.


Whatever you’re facing, you don’t have to go through it alone.
We offer several different types of mental health and wellbeing support, and you can choose the service that works best for you. Options include self-help resources, workshops, courses, confidential one-to-one counselling or group wellbeing sessions. We can also signpost you to additional support services that might be helpful.
If you’re worried your studies might be affected, we can work with your academic team to put the right support in place – for example, getting extra time to complete your coursework.
Comprehensive support is in place for any student with a disability or longterm medical condition. The sooner you tell us about it, the sooner we can put plans in place – it could be anything from accessing specialist equipment to help with planning your academic writing assignments. Your support package will be tailored to whatever it is you need to excel here at Cardiff Met.

Develop the skills and strategies to overcome any study challenges with our specialist learning support. This can take the form of one-to-one specialist tutor and mentor appointments or workshops on topics like academic writing, presentations or proofreading. You can also access a host of specialist online resources to help you learn more effectively.
Or it might be that you need support with temporary challenges like workload planning or adjusting to university life. We can help with that too.
Get specialist support for your financial concerns, whether they’re around budgeting, funding or overspending. Need urgent help? We also offer an emergency support fund to eligible international students who are facing financial hardship.
Questions?
Visit: www.cardiffmet.ac.uk/ studentservices for more information on our student support. We’re ranked in the
Scan or click to visit Student Services

It’s never too early to start thinking about your career and where you want it to take you.
From the day you enrol here, you’ll have access to our selection of employability services to help you fulfil those big ambitions – or just get a better idea of what kind of career would suit you. And the support is lifelong after you graduate.

Tailored to international students
As an international student, you’ll have a specialist careers team dedicated to helping you with your career goals. You can get year-round, impartial, professional advice on everything from CV reviews and interview tips to learning about UK working practices. We can also help you apply for parttime work, internships, placements and work experience.




You can access our jobs portal showcasing internships, as well as fulltime opportunities with companies that have a Skilled Worker visa sponsorship licence – so you could potentially stay and work in the UK after you graduate.
And, of course, you can also get involved in those activities open to every Cardiff Met student. As part of our Shape Your Future initiative, you can compare your skill levels against those that are most in-demand by employers. At our annual Careers Fair, held here on campus, you can explore the job market and meet potential employers from across the UK.



Help for entrepreneurs
Why wait until after you graduate to start chasing your dream? If you’re ready to start your own business, charity or social enterprise, you can tap into all the services offered by our Centre for Entrepreneurship.
We can take you step-by-step through starting your own organisation, as well as offering support with a range of funding for your start-up.
You can also develop both your ideas and your entrepreneurial skills through our busy programme of networking and experiential learning events, bootcamps, workshops and courses, run every year for our students and graduates.
96.3% of our graduates are in work or further study 15 months after completing their course
Graduate Outcomes Survey, June 2024



Scan or click to visit entrepreneurship

Immerse yourself in the vibrant, community of Cardiff School of Art & Design, as you expand your skills, ideas and experiences ready for a career in the creative industries. You’ll become a multi-faceted and highly skilled graduate ready to join the leaders, thinkers and entrepreneurs of the future.
Based at our Llandaff Campus, our expansive range of purpose-built workshops are staffed by experts, helping you to become a skilled creative practitioner with a varied and dynamic skillset. You’ll get hands-on experience with real-world briefs, as well as work with industry leaders and professional practitioners in preparation for your future career.
From printmaking, architecture, product design, ceramics and more, you’ll push the boundaries of your discipline whilst working alongside other artists, designers and makers in a collaborative and supportive studio environment. Whatever you choose, our pioneering interdisciplinary curriculum will help you to bring your creative vision to life.

Scan or click to visit Cardiff School of Art & Design
With our capital city location, purposebuilt, multi-million-pound facilities and opportunities for international travel, Cardiff School of Art & Design is the ideal place to continue your creative journey.
Here’s a taste of the courses on offer:
MA Ceramics & Maker
MA Illustration & Animation
MA Interior Design
MA Visual Communication Design
MSc Product Design
BA Architecture
BA Fashion Design
BA Fine Art
BA Interior Design
BSc Product Design
Scan or click the QR code below to see the full range of courses available.



“As an international student studying architecture, I’ve found our lecturers to be incredibly supportive, always willing to patiently explain concepts multiple times until everyone grasps them fully.
What truly stands out is the academic support system in place. From tutors assigned to each student, to one-on-one consultations, study groups, and Cardiff Met’s dedicated online platform ‘MetSearch’, there’s a plethora of resources available to ensure every student receives the assistance they need to excel.”
Anna Vlachopoulou Architecture BA (Hons)















Innovative, practice-based learning forms the foundation of our range of education, teacher training, English, creative writing, media and social policy courses.
We have over 75 years’ experience and an enviable reputation for the quality of our education and teacher training provision. The School is home to the Cardiff Partnership for Initial Teacher Education, one of the largest centres of teacher education and training in the UK.
Our extensive specialist facilities at the Cardiff School of Education & Social Policy include an outdoor learning centre, science and psychology laboratories, art and design workshops, media and IT suites, music studio and education library.
Criminology and policing students are also taught in our moot courtroom and crime house, which incorporates a custody suite, observation and surveillance suite, and a suspect interview room.

Outside of the University walls, you'll have an opportunity to take part in work placements with schools, industry, professional bodies and the local community. So you’ll be fully prepared for the world of work when you graduate.
Here’s a taste of the courses on offer:
MA Education
MA TESOL
PGCE Primary
MSc Psychology in Education
MRes Education
BA English & Creative Writing
BA Media & Communications
BSc Criminology
BSc Health & Social Care
BSc Social Work
Scan or click the QR code below to see the full range of courses available.
Scan or click to visit Cardiff School of Education & Social Policy



“I am really enjoying my experience at Cardiff Met. As a result of what I am learning on the MA TESOL, I now have more confidence in my teaching style, and I am learning to adapt to different styles of teaching practice. The University has been extremely supportive and has helped me develop and grow as both a student and a person.”
Son Tung Bui TESOL (Teaching English to Speakers of Other Languages) MA




Become a business leader of the future and meet the demands of an ever-changing business landscape with our courses, created in collaboration with industry leaders, academic experts and accredited professional bodies.
At the Cardiff School of Management, you can choose from a range of employability focused courses across accounting, economics and finance; business and management; law; marketing; tourism, hospitality and events management.
Our curriculum is driven by pioneering research and the real-world experience of our renowned academics, offering a learning environment that is both supportive and intellectually stimulating.
That, combined with specialist, purpose-built facilities – which include a mock courtroom, IT centres and onsite hospitality suite with adjoining kitchens – are some of the many reasons why we’re one of the leading centres in the UK for business and management education.
We offer a range of courses in addition to those highlighted below:
MBA
MSc Accounting & Finance
MSc International Business Management
MSc International Supply Chain & Logistics Management
MSc Project Management
BA Accounting & Finance
BA Business & Management
BA International Hotel & Hospitality Management
BA Marketing Management
LLB Law
Scan or click the QR code below to see the full range of courses available.
Please note that a select number of undergraduate and postgraduate courses start in January or May as well as September.




“One of the most rewarding aspects of studying at Cardiff Met was the opportunity to interact with a diverse cohort of international students. Collaborative projects allowed us to harness the collective strength of different cultural backgrounds, providing a glimpse into the global dynamics of project management.
Cardiff, the vibrant capital of Wales, served as the backdrop to my academic journey. From the historic Cardiff Castle to the lively atmosphere of Cardiff Bay, the city offers a perfect blend of history and modernity. Engaging with the local culture was an integral part of my experience, and the friendly Welsh community made me feel at home.”
Parand Parsa Project Management MSc









With our courses combining theoretical study, lab work and practical experience in different settings, you’ll be ready to embark on a career that can make a lasting difference to people’s lives.
As part of the Cardiff School of Sport & Health Sciences, you’ll train in a recognised centre of excellence in the UK, one with an international reputation for the quality of its research and academic work.
Our facilities rival those used in industry. The new Allied Clinical Health Hub is a sector leading facility used to provide authentic healthcare training. Other facilities also include health assessment suites, dental technology and biomedical science labs – as well as a food industry centre, podiatry clinic, and speech and language therapy clinic.
Here’s a taste of the courses on offer:
MSc Applied Public Health
MSc Advanced Practice in Healthcare
MSc Biomedical Science
MSc Food Science & Technology
MSc Occupational Safety, Health & Wellbeing
BSc Biomedical Science
BSc Dental Technology
BSc Environmental Health
BSc Food Science & Nutrition
BSc Psychology
Scan or click the QR code below to see the full range of courses available.
“I volunteered as a Student Ambassador for the Spring Conference, conducted by the Institute of Food Science and Technology (IFST), which was an enriching experience. I acquired a wealth of knowledge about food security, health and nutrition, and the environment. I also got to broaden my network. I got the opportunity to visit OP Chocolate Ltd, where we were taken inside the factory to see how each of the processes took place.”

Sharon Alexander Food Science and Technology MSc

Or you can explore the latest approaches in sport in our rehab and conditioning gym, strength and power gyms, massage teaching room, world-leading performance analysis lab, physiology lab and biomechanics department and our sport broadcast suite.
In these specialist facilities, you can put your skills and knowledge into practice. As part of your course, you’ll have opportunities to gain real-world experience offering clinical or sport-related services to your peers and the local community. Here’s a taste of the courses on offer:
MSc Sport & Exercise Science
MSc Sport Coaching
MSc Sport Psychology
MSc Sport Rehabilitation
MSc Strength & Conditioning
BSc Sport & Exercise Science
BSc Sport Coaching
BSc Sport Conditioning, Rehabilitation & Massage
BSc Sport Management
BSc Sport Media
Scan or click the QR code opposite to see the full range of courses available.



“My internship at the Newport Dragons not only bolstered my competence in working with elite, male athletes but also gave me the opportunity to learn from some of the top rugby coaching staff and athletes in the world.”
Mollie Martin Strength and Conditioning MSc





















Developed in partnership with leading tech companies, courses at the Cardiff School of Technologies train you to take on the challenges of an ever-evolving digital world.
You’ll become part of our thriving, tight-knit community of people who are passionate about tech. Taught by a network of experts – including leading academics and practitioners with ties to industry – you’ll learn the theory and research behind your chosen subject.
Here, we also learn through doing. You can explore all aspects of technology through hands-on training in our extensive labs and facilities built exclusively for our Technologies students: a robotics lab, computer security lab, games lab, electronic systems lab, data science or AI lab. The school's communal spaces are designed for work and relaxation, featuring amenities like video game machines, foosball table and VR booths to create an ideal environment for both.
Depending on which course you choose, you’ll also have opportunities to take year-long placements, compete in industry-based hackathons, Game Jams or explore opportunities abroad with our academic partners.
Here’s a taste of the courses on offer:
MSc Advanced Computer Science
MSc Advanced Cyber Security
MSc Computing & Information Technology
MSc Data Science
MSc Robotics & Artificial Intelligence
BSc Computer and Data Science
BSc Computer Science
BSc Computer Security
BSc Software Engineering
BEng Robotics Engineering
Scan or click the QR code below to see the full range of courses available.

Scan or click to visit Cardiff School of Technologies





“During my studies, I had the opportunity to work as a Software Engineer intern at Techno Brain Microsoft. Within a month and a half, I learnt how to install software packages, test applications and analyse results. I even began coding in my free time!”
Nirav Challa Computer Science BSc (Hons)













Fees for studying at our Llandaff and Cyncoed campuses in the UK.
Undergraduate courses Length Fees for 2025/26
Undergraduate degree Three to four years
£16,000 per year
Top-up degree One year £16,000
Postgraduate courses Length Fees
Master’s degree (not including our MBA) One to two years
£17,600
Master of Business Administration (MBA) One year £19,500
Postgraduate Doctoral degree (PhD) Varies £17,600 per year
Postgraduate Certificate in Education (PGCE) One year £14,000
Placement/ Year in Industry One year £1,800
Other courses Length Fees
Pre-sessional English Six to 14 weeks Fees vary –please see our website for more details
International foundation course One year £12,000
Please check our website for the most up-to-date fees. Some of our courses have additional mandatory or optional costs, which you’ll need to pay in order to complete your studies. These costs are outlined on individual course pages on our website.


According to UKVI, you should budget around £1,023 per month to cover your living expenses whilst studying in Cardiff.

International scholarships
We offer a range of scholarships to help ease the cost of studying in the UK. You’ll find an overview below, but more details –including eligibility criteria and how to apply – can be found on our website.
Undergraduate students
When we receive your application, you’ll automatically be considered for one of our undergraduate scholarships of up to £2,500. If you’re successful, we’ll let you know in your offer letter.
Postgraduate students


Cardiff Met Sanctuary Award If you’re an undergraduate or postgraduate applicant with an irregular immigration status*, you can apply for one of our Cardiff Met Sanctuary Award scholarships. They cover all of your tuition fees and include financial support towards your study costs.
*Applicants who are already in the UK with an irregular immigration status
We accept a wide variety of international academic qualifications and, in some cases, relevant work experience. It all depends on which course you’d like to apply for – please check the individual course page on our website for more details of what we’re looking for.
Proof of your English language skills
If English isn’t your first language, you’ll need to show that you meet our minimum English language requirements.
You won’t need to do this if you’re a national of a majority English-speaking country – or if you’ve completed an academic qualification (equivalent to a UK degree) in a majority Englishspeaking country.
Qualification
IELTS Academic
Pearson Test of English Academic (PTE Academic)
TOEFL IBT (Internet Based Test)
C1 Advanced (Previously Cambridge English Advanced)
Accepted English language qualifications
Please note that you may need a higher overall score or subscore for certain courses – check the specific course page for more information.

Undergraduate and standard postgraduate requirements Higher level courses
Overall score: 6.0 (with no component below 5.5)
Overall score: 59 (minimum score required in each skill area is 59)
Overall score: 72
Minimum scores required in each skill area are: Reading: 18, Listening: 17, Writing: 17 Speaking: 20
Overall score: 169 with no component score lower than 162
Trinity College London ISE II pass with minimum merit in each skill
LanguageCert Academic SELT (online not accepted)
Overall score: 65 with no score lower than 60
6.5 overall with 6.5 in both reading and writing, and a minimum of 6.0 in the remaining components
Overall score: 62 (minimum score in reading and writing: 62, speaking and listening: 59)
Overall score: 83
Minimum scores required in each skill area: Reading: 19, Listening: 20, Writing: 24, Speaking: 20
C1 is 180-199, upper middle would be 195+, lower middle would be 185+
ISE II pass with distinction in each skill/ISE III pass with pass in each skill
Overall score: 70 with minimum 70 in both reading and writing and minimum 65 in speaking and listening


Need a bit of extra English language support?
You can apply for a range of classes, tuition language and study skills support at our English Language Training Centre (ELTC), which is based at our Cyncoed campus.
International Foundation
This course, lasting one academic year, helps you to develop your English language and academic study skills, so you can be fully prepared to start a course in the UK at undergraduate or postgraduate level.
If you complete the International Foundation, you’ll be awarded with 120 Level 3 credits. We’ll then help you to apply for your chosen undergraduate or postgraduate course here at Cardiff Met.
To be eligible, you must have an overall IELTS level of 4.5 or above (or an equivalent grade) and a minimum IELTS of 4.0 in each component (or equivalent).

Pre-sessional summer courses
These full-time courses can help you improve your English language skills so you’re able to meet our entry requirements to study at undergraduate or postgraduate level. Courses range from six weeks to 14 weeks.
Bespoke courses and individual tuition
We can also create an English language study programme tailored to your specific goals – choose from private or small group tuition.
Questions?
Email: askinternational@cardiffmet.ac.uk

Most of our courses start in September. However, we also have a select number of undergraduate and postgraduate courses in the School of Technologies and School of Management that start in January or May.
International Foundation
You can apply via the free online application form on our website.
Undergraduate
As an international applicant, there are several ways you can apply:
Free online application form on our website (September and January intakes)
University and College Admissions Service (UCAS) website (September intake only)
Postgraduate
You can apply via the free online application form on our website.



Receive unconditional offer
Accept our offer
Pay tuition fee deposit
Sign into CAS Shield and upload required information
Receive Confirmation of Acceptance for Studies (CAS)

Choose your course
Submit your application and supporting documents (via Cardiff Met or UCAS)
Receive and accept unconditional offer
Receive conditional offer
Accept offer
Send proof of conditions to Cardiff Met
Apply for your visa
Apply for, or research, accommodation
Welcome to Cardiff Met
What do I need to submit with my application?
Copies of your exam certificates and transcripts
Personal statement (not required for International Foundation applicants)
Copy of your English language certificate or NARIC Statement of Comparability (if applicable)
One educational reference or two employer references, if you’re applying based on work experience
Evidence of your sponsorship (if applicable)
Copy of your portfolio (Art & Design courses only)
Evidence of your sporting achievements (Sport courses only)
Contact us
e: askinternational@cardiffmet.ac.uk
t: +44 (0)29 2041 6045
w: cardiffmet.ac.uk/international
Cardiff Metropolitan University, Western Avenue, Cardiff, CF5 2YB
Join our community

UK’s 6th most sustainable university 2023/24 University of Sanctuary

/cardiff.metropolitan.university /cardiffmet
/cardiffmet
@cardiffmet
/@cardiffmet
/school/cardiff-metropolitan-university/
Important information
This guide was produced in September 2024. Information is correct at the time of production and refers to the intended offer for students commencing study in the 2025/26 academic year. Prospective students should refer to our website for the most up-to-date course information and entry requirements before making an application.
It may be necessary for the University to make changes in course provision or services due to legitimate staffing, financial, regulatory, or academic reasons. Where factors outside the control of the University impact delivery, every reasonable step will be taken to minimise disruption and to communicate changes to applicants. Please read our Terms and Conditions for full information: www.cardiffmet.ac.uk/terms
